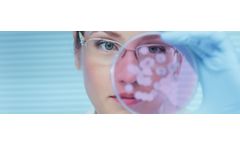
Clinisys - Microbiology Laboratory Solution

- Home
- Services
Refine by
Clinisys Environmental Industry Services
11 services found
by:Clinisys, Inc. based inTucson, ARIZONA (USA)
Ensuring clean, safe drinking water for communities. Clinisys Water Quality Laboratory offers all the benefits of a modern laboratory information management system (LIMS), providing a flexible solution to support your entire testing workflow, both inside and outside the lab. Automation eliminates paper, improving efficiency and quality. Integration ensures effective instrument data collection, ...
by:Clinisys, Inc. based inTucson, ARIZONA (USA)
Transform your laboratory: Ensure your lab remains competitive by choosing and using a future-proof lab solution, designed for the cloud and ready for artificial intelligence. Clinisys Laboratory Solutions™ speed up workflow and simplify processes across end-to-end lab operations within a wide range of industries and ...
by:Clinisys, Inc. based inTucson, ARIZONA (USA)
Testing the next generation of crops. Clinisys Crop Sciences Laboratory supports a wide variety of agricultural testing requirements, including food safety, seeds, plants, crops, fertilizers, pesticides, soil, water, and environmental tests. Our solution provides flexible workflow to ensure your agricultural lab’s productivity and ...
by:Clinisys, Inc. based inTucson, ARIZONA (USA)
Improve productivity and accelerate drug testing. Clinisys Toxicology Laboratory offers you all the benefits of a modern laboratory information management system (LIMS), supporting the workflow and processes used to test for legal and illegal drug use, monitor addiction treatments, conduct pain management and undertake forensic toxicology services. Our solution helps labs streamline and increase ...
by:Clinisys, Inc. based inTucson, ARIZONA (USA)
Serving contract research organizations. Clinisys supports contract research and laboratory services organizations operating within all stages of the research, testing, commercialisation, and production lifecycle. Our lab customers serve clients within a broad spectrum of industries, including healthcare, life sciences, pharmaceuticals, biotechnology, agriculture, food, water, and utilities. ...
by:Clinisys, Inc. based inTucson, ARIZONA (USA)
Improve quality and productivity. Providing all the benefits of a laboratory information management system (LIMS), Clinisys Contract Services Laboratory supports all the essential workflow and processes of contract services labs operating in healthcare, life sciences, pharmaceuticals, biotechnology, agriculture, food, and ...
by:Clinisys, Inc. based inTucson, ARIZONA (USA)
A microbiology solution for the modern laboratory. Offering all the advantages of a modern laboratory information management system (LIMS), Clinisys Microbiology Laboratory encompasses Bacteriology, Virology, Infection Control, Environmental and Epidemiology services. Our solution supports paperless processes allowing you to build, customise, and control your unique laboratory workflow. ...
by:Clinisys, Inc. based inTucson, ARIZONA (USA)
End-to-end workflow and compliance: Clinisys Environmental Laboratory offers you all the benefits of a modern laboratory information management system (LIMS) providing the full range of testing scenarios, processes and workflows required to deliver against the diverse needs of environmental labs, whilst also managing compliance and ensuring ...
by:Clinisys, Inc. based inTucson, ARIZONA (USA)
Meeting the challenge of new regulations and automation. Clinisys supports environmental labs testing soil, air, water, wastewater, solids, biomonitoring, and microbiology. Our environmental lab solution, the Clinisys Laboratory Solutions (CLS), meets the challenge of an increasing regulatory burden by efficiently satisfying your quality assurance and compliance needs using embedded sample ...
by:Clinisys, Inc. based inTucson, ARIZONA (USA)
Market Leading Laboratory Information System. Our high-performance laboratory information solution is relied upon by healthcare professionals to test, diagnose and treat millions of patients every day, helping to save or improve quality of life. Our fully scalable and interoperable system is intuitive to use, minimises manual tasks and allows your team to get more done in less ...
by:Clinisys, Inc. based inTucson, ARIZONA (USA)
Ensuring the safety and quality of food. Offering all the benefits of a specialist laboratory information management system (LIMS), Clinisys Food & Beverage Laboratory provides an end-to-end solution covering the complete testing process for food and beverage labs. Automation eliminates paper, improving the efficiency of test processes and simplifying audit and regulatory ...